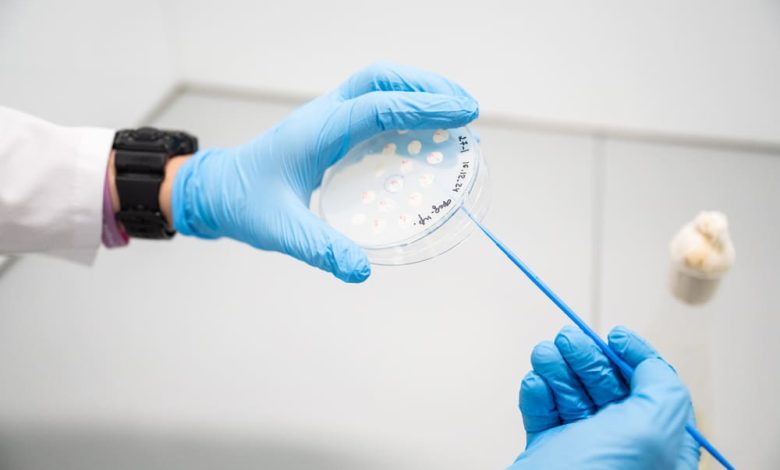

Гель на основе фермента декстраназы: новая разработка российских учёных против зубного налёта
Учёные Национального исследовательского технологического университета «МИСИС» представили инновационную разработку для профилактики кариеса — специальный гель на основе фермента декстраназы. Разработка, созданная молодыми исследователями под руководством учёных кафедры общей и неорганической химии, способна эффективно разрушать зубной налёт и предотвращать развитие стоматологических заболеваний, а в будущем может лечь в основу улучшенных зубных паст и новых профилактических средств.
Особенностью новой технологии является использование методов направленного биосинтеза и генной инженерии. Исследователи создали генетическую конструкцию, которая позволяет специально выведенным метилотрофным дрожжам Pichia pastoris производить необходимый фермент декстраназу в больших количествах. Как пояснил кандидат химических наук, доцент Павел Волков, этот подход даёт возможность целенаправленно создавать ферменты с заданными свойствами, регулируя, например, вязкость геля, его способность разрушать бактериальные биоплёнки или антибактериальную активность для решения конкретных задач в стоматологии.
Важным преимуществом использования штамма дрожжей Pichia pastoris является высокая чистота конечного продукта. Как отметил студент НИТУ МИСИС Ярослав Горинов, данный штамм не синтезирует посторонние белки и метаболиты, что исключает одну из самых затратных стадий производства — хроматографическую очистку. Эта разработка принесла молодому учёному победу и грант в размере 1 миллиона рублей в конкурсе «Студенческий стартап» Платформы университетского технологического предпринимательства.
Таким образом, внедрение метода направленного биосинтеза открывает перспективы для создания доступных и эффективных средств гигиены полости рта. Технология позволяет не только удешевить и упростить процесс производства ферментов, но и получать вещества, целенаправленно борющиеся с бактериальными плёнками — основной причиной кариеса и других заболеваний зубов.